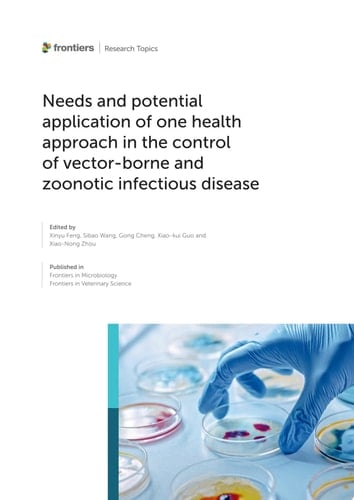
Needs and potential application of one health approach in the control of vector-borne and zoonotic infectious disease

Needs and potential application of one health approach in the control of vector-borne and zoonotic infectious disease
0
0
Author Description
Page Count:
153
Publication Date:
2022-12-23
ISBN-10:
2832509568
ISBN-13:
9782832509562
Community Tags
Reader Comments
Share Your Thoughts
No comments yet. Be the first to share your thoughts!